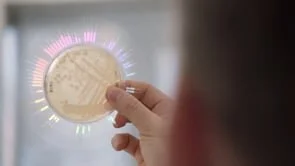

Teague x Chapeau
We Are Chapeau
Chapeau Studios has a reputation for delivering bespoke, high-quality creative solutions for the world’s most ubiquitous brands.
Our talented people and best-in-class technologies provide efficient and flexible global solutions to our clients’ creative challenges.
Live Action Production
Pre-Visualization
Docu-Narrative
Remote/Safe Distancing Production Solutions
Motion Graphics, Design & Animation
UI Animation
Editorial Solutions
You’ve shot plenty of footage in the past, and some of it is still on the cutting room floor. This is the time to put that footage to work. Incorporating compositing, motion graphics and CG, our creative editors can help freshen and uplift your library footage to give it new life during pandemic production shutdowns.
Consumers have their own libraries too. The world has never had more cameras capturing engaging footage. Recontextualizing stock footage or old media along with UGC submissions is an ever-more prominent form of content, one in which Chapeau is well-versed.
Old Footage, Made New (Again)
User-Generated Content
Compositing & Finishing
Compositing has traditionally been our most powerful and reliable tool, and remains so today. Any form of still photograph, archival or library footage, user-generated content, motion graphics or CG element can be refreshed, combined, and redesigned to create something new.
Chapeau built its reputation on perfectionist compositing and finishing, so even as we have expanded into other visual mediums, we revere them as some of our most robust core competencies.
Color
Photoreal CG
With photoreal product CG, virtual cameras can go where live action cameras only dream of. CG cameras with real physics and artistic lighting can make your product the hero (in or out of quarantine).
New & Experimental Tech
Deep capabilities in high-end film & video content, digital design, and engineering enable Chapeau to be a category-defining creative studio.
We are focused on the future. Challenges like personalized generative video and virtual production require inventive, interdisciplinary solutions to future-facing problems, and problem-solving inspires us.
At the same time, we remain loyal students of the fundamentals of beautiful imagery: framing, contour, shadow, and light.
Personalized & Algorithmic Videos
Working with Facebook, Chapeau pioneered a form of dynamic compositing. Over several years, we created celebrations of Facebook friendships that elevate users’ own content from mere assets into delightful films.
We created live-action design films (with CG and 2D animation elements) that used our dynamic compositing process to deliver “live” video files, which were turned into millions of personalized videos.
“Friends Day” was the first widely-seen generative film, followed by “Friendversary”. When it debuted in 2016, there were more than 1 billion “Friendversary” films made, in 35 languages. Today, more than 200,000 personalized versions of this now-iconographic video are still being rendered daily.
XR - Environments
The same shoot can utilize multiple environment options for a single shot or photograph. With virtual production, it can be golden hour all over the world in a single shoot day if you need it to be.
Alt Backgrounds
XR - Talent Options
What may work for one demographic or region is likely different for another, so why not cover diversity and use Chapeau’s virtual production capabilities to take talent all over the world without the hurdles or costs of flights, hotels, and time zone changes.
Alt Background
POC / For Visual Reference